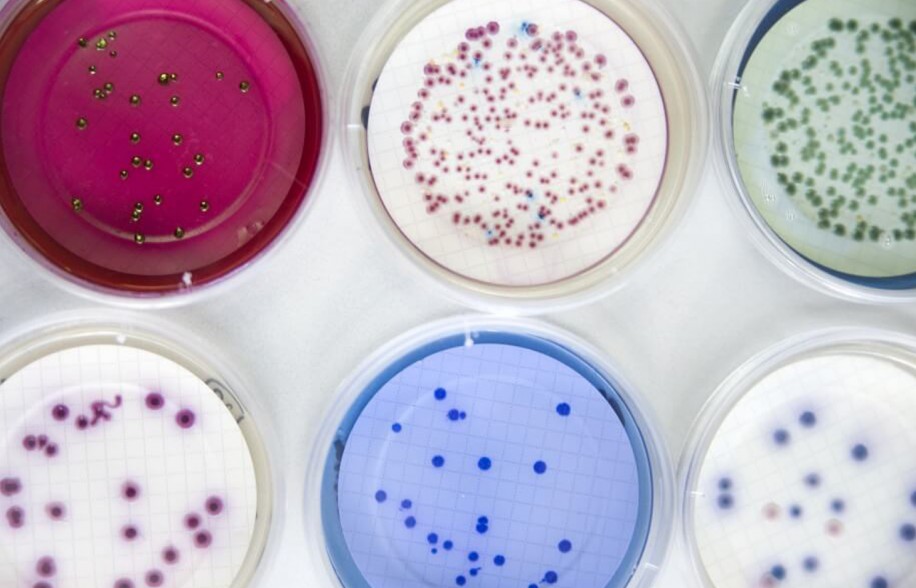

Laboratori
El Laboratori de l’Agència de Salut Pública de Barcelona es va crear l’any 1887. Al llarg dels anys ha evolucionat per adaptar-se a les necessitats de la salut pública a la ciutat, i l’any 2003 va experimentar una gran transformació amb la integració dels recursos humans i materials del Laboratori de Salut Pública de la Generalitat de Catalunya a Barcelona.
El Laboratori contribueix a la identificació i control de problemes de salut pública a la comunitat mitjançant el suport analític als programes de vigilància de la seguretat alimentària i medioambiental, de vigilància epidemiològica i de control de les malalties infeccioses que realitzen altres serveis de l’Agència de Salut Pública de Barcelona i del Departament de Salut de la Generalitat.
Actualment al Laboratori disposem de més de 1.000 paràmetres analítics de referència emparats per l’acreditació ISO 17025:2005, atorgada per l’Entitat Nacional d’Acreditació (ENAC). La moderna instrumentació i el fet de tenir l’abast d’acreditació flexible fan que puguem donar resposta a problemes emergents derivats del control de la seguretat alimentària que porten a terme les diferents administracions públiques.
L’ oferta analítica del Laboratori també està disponible, d’una banda, a persones particulars, i de l’altra, a empreses i indústries agroalimentàries i a laboratoris públics i privats que vulguin assegurar la qualitat i seguretat dels seus productes d’acord amb la legislació alimentària vigent.
Totes les activitats analítiques que realitza el Laboratori es regeixen pel criteri tècnic, garantint la seva imparcialitat, independència i integritat. De la mateixa manera, el Laboratori es compromet a mantenir la confidencialitat de tota la informació que es derivi d’aquestes activitats.












